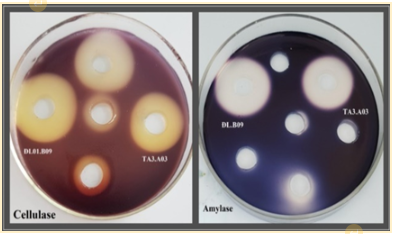

ĐÁNH GIÁ HIỆU QUẢ BẢO QUẢN ĐÔNG KHÔ CHỦNG VI KHUẨN VÀ XẠ KHUẨN BIỂN BẰNG KỸ THUẬT TIỀN XỬ LÝ LẠNH SÂU VÀ SỬ DỤNG CHẤT BẢO VỆ
Phân viện Công nghệ sinh học, Trung tâm Nhiệt đới Việt - Nga
63 Nguyễn Văn Huyên, Nghĩa Đô, Cầu Giấy, Hà Nội, Việt Nam
Số điện thoại: 0974056143; Email: tuyendodhkh@gmail.com
Nội dung chính của bài viết
Tóm tắt (Abstract)
EVALUATE THE EFFICIENCY OF FREEZE-DRYING PRESERVATION OF MARINE BACTERIAL AND ACTINOMYCETE STRAINS BY DEEP FREEZING PRETREATMENT TECHNIQUES AND THE USE OF PROTECTANTS
This study aimed to evaluate the effect of deep freezing pretreatment techniques and the protectants on the efficiency of freeze-drying preservation of Bacillus amyloliquefaciens ĐL01.B09 (Genbank OQ415515) and Streptomyces sp. TA3.A03 (Genbank OQ415510) isolated from marine sediments in Truong Sa archipelago (Spratly Islands), Khanh Hoa province. The results showed that the survival rate of both strains ĐL01.B09 and TA3.A03 in the sample pretreatment formula at -80°C was higher than at -20°C and higher than the control without deep freezing pretreatment, the survival rate reached 71% with actinomycetes and 73% with bacteria. When the two microorganism strains were deep freezing pretreatment combined with the use of protectants including lactose, sucrose, trehalose, and skim milk, their survival rates were 51% - 80%, which is significantly greater than the control (21% - 18%). Using a combination of protectants including trehalose 10%, skim milk 10%, sodium glutamate 1% and NaCl 0.9% and deep freezing pretreatment at -80°C provided the best protective effect, the survival rates were 91%-88% and the density of microorganisms after freeze-drying reached ≥ 1010 CFU/mL. The quality of freeze-dried microbial strains met Vietnam's standard TCVN 6168 - 2002 after 15 months of preservation at room temperature.
Từ khóa (Keywords)
Freeze-drying preservation, protectants, survivability, deep freezing pretreatment technique, marine microorganisms, Truong Sa archipelago (Spratly Islands), bảo quản đông khô, chất bảo vệ, khả năng sống sót, kỹ thuật tiền xử lý lạnh sâu, vi sinh vật biển, quần đảo Trường Sa
Chi tiết bài viết
1. ĐẶT VẤN ĐỀ
Bảo quản lâu dài các chủng giống vi sinh vật có tầm quan trọng đặc biệt, làm nền tảng cho các nghiên cứu cơ bản và ứng dụng liên quan đến nhiều lĩnh vực: sinh học, y học, nông nghiệp và môi trường. Mục đích của bảo quản không những là duy trì khả năng sống sót của vi sinh vật, thuần chủng, tránh tạp nhiễm mà còn đảm bảo tính ổn định di truyền và các đặc tính sinh học trong suốt quá trình bảo quản. Thông thường, phương pháp bảo quản lạnh sâu (ở -20°C, -80°C hay -196°C) sử dụng các trang thiết bị chuyên dụng như tủ bảo quản đông lạnh, bình chứa nitơ lỏng để duy trì liên tục trạng thái bảo quản được sử dụng phổ biến hiện nay. Tuy nhiên, trong thực tế việc không đảm bảo duy trì nguồn điện liên tục hay không kịp thời bổ sung nitơ lỏng có thể làm ảnh hưởng tới khả năng hồi phục của chủng giống, gây mất mẫu, cũng như tổn thất về thời gian và kinh tế. Trong khi đó, việc duy trì các thư viện mẫu lớn sử dụng phương pháp bảo quản lạnh sâu đòi hỏi không gian lớn với hệ thống tủ đông lạnh, các chi phí duy trì bảo quản cũng như công tác vận chuyển mẫu gặp nhiều khó khăn [1]. Nhằm khắc phục những hạn chế trên, phương pháp bảo quản đông khô đã được sử dụng linh hoạt, thích hợp bảo quản vi sinh vật và bảo quản các vật liệu sinh học nhạy cảm với nhiệt độ như protein và vắc xin ở điều kiện nhiệt độ môi trường trong thời gian dài [1, 2]. Đây cũng là phương pháp phổ biến được sử dụng tại các bảo tàng vi sinh vật trên thế giới và một số đơn vị nghiên cứu ở Việt Nam đã được trang bị thiết bị đông khô chuyên dụng.
Đông khô là quá trình tách nước từ các mẫu đã được làm lạnh sâu bằng quá trình thăng hoa, theo đó đình chỉ nhanh chóng các quá trình trao đổi chất của vi sinh vật và chuyển hoá tế bào thành dạng bột khô giúp thuận lợi trong quá trình bảo quản dài hạn ở điều kiện nhiệt độ phòng [2, 3]. Tuy nhiên, việc hình thành các tinh thể băng trong quá trình đông khô được biết là gây bất lợi cho vi sinh, làm tổn hại nghiêm trọng đến màng tế bào và protein, gây giảm khả năng tồn tại của tế bào, tỷ lệ sống sót thấp tới 0,1% sau đông khô chủng giống đã được báo cáo [4]. Để khắc phục khó khăn trên, tuỳ điều kiện thực tế mà trước khi tiến hành đông khô, huyền phù vi khuẩn có thể được tiền xử lý lạnh sâu ở các điều kiện nhiệt độ -20°C, -80°C hay trong nitơ lỏng -196°C [5, 6]. Đồng thời, việc bổ sung các chất bảo vệ thuộc nhóm disaccharides (như trehalose, sucrose, lactose) và protein (skim milk) trước khi tiền xử lý lạnh sâu giúp ngăn ngừa tổn thương cho các tế bào [7, 8]. Một số nghiên cứu cũng chỉ ra việc kết hợp giữa skim milk tỷ lệ 10% (w/v) với một số thành phần khác như natri glutamat, trehalose, rafinose hay mật ong giúp tăng khả năng sống sót của tế bào Saccharomyces cerevisiae từ 30% lên 96 - 98% [3]. Hầu hết các mẫu bảo quản đông khô có thể được lưu trữ trong ít nhất một năm mà không đòi hỏi duy trì trạng thái bảo quản đặc biệt, với một số nguồn vi khuẩn có thể tồn tại trong vài thập kỷ khi được bảo quản đúng cách [9]. Các mẫu cấy đông khô có thể được phục hồi đơn giản bằng cách bù nước hoặc dung dịch muối đệm phosphate (PBS) trước khi cấy chuyển vào môi trường dinh dưỡng mới [2, 5]. Phương pháp bảo quản này có hiệu quả với những chủng vi sinh vật có nhiều đặc tính quý thuộc các nhóm vi sinh vật khác nhau như nấm sợi, nấm men, vi khuẩn, xạ khuẩn [2, 10, 11].
Môi trường biển là nơi có hệ sinh thái đặc thù với độ mặn nước biển > 30 ‰. Quá trình sinh trưởng phát triển trong môi trường có nồng độ muối cao đã tạo ra nhiều đặc tính thích nghi ở các chủng vi sinh vật, có liên quan tới các đặc điểm về hình thái, đặc điểm sinh lý sinh hoá cũng như sự hình thành một số hoạt chất sinh học đặc trưng. Vì vậy, việc nghiên cứu bảo quản các chủng giống vi sinh vật biển không những là yêu cầu cấp thiết mà còn đòi hỏi có những nghiên cứu theo dõi phương pháp bảo quản phù hợp để bảo tồn, duy trì và cung cấp nguồn dữ liệu giống vi sinh vật của Việt Nam. Mục đích của nghiên cứu này nhằm đánh giá ảnh hưởng của việc sử dụng kỹ thuật tiền xử lý lạnh sâu và các chất bảo vệ tới hiệu quả của quá trình bảo quản đông khô chủng vi khuẩn Bacillus amyloliquefaciens ĐL01.B09 (Mã đăng kí Genbank OQ415515) và chủng xạ khuẩn Streptomyces sp. TA3.A03 (Mã đăng kí Genbank OQ415510) có nguồn gốc phân lập từ trầm tích biển thuộc khu vực quần đảo Trường Sa, tỉnh Khánh Hòa. Một số đặc điểm về hình thái, sinh lý, sinh hóa và khả năng sinh enzym ngoại bào của các chủng này đã được khảo sát và ghi nhận [12, 13].
2. ĐỐI TƯỢNG VÀ PHƯƠNG PHÁP NGHIÊN CỨU
2.1. Đối tượng nghiên cứu
Chủng vi khuẩn Bacillus amyloliquefaciens ĐL01.B09 và xạ khuẩn Streptomyces sp. TA3.A03 thuộc Phòng Thí nghiệm Phân viện Công nghệ sinh học, Trung tâm Nhiệt đới Việt - Nga. Trong đó, chủng ĐL01.B09 có nguồn gốc phân lập từ các mẫu trầm tích biển thu ở độ sâu 8 m thuộc đảo Đá Lát, chủng TA3.A03 phân lập từ mẫu trầm tích biển thu ở độ sâu 2 m thuộc đảo Đá Tây A, khu vực Quần đảo Trường Sa, tỉnh Khánh Hòa.
2.2. Trang thiết bị, dụng cụ, hóa chất
- Trang thiết bị: máy sấy đông khô chân không ALPHA 1-2 LD plus, tủ lạnh sâu UltraLow Temperature Freezer MDF-U33V (Panasonic, Japan), tủ lạnh sâu Biomedical Freezer MDF-136 (Sanyo, Japan) và một số trang thiết bị chuyên dụng khác.
- Môi trường sử dụng [14]:
+ Môi trường GYP: 10g peptone - 5 g cao nấm men - 20g glucose - nước cất 1 lít.
+ Dung dịch đệm PBS: 8 g NaCl - 0,2 g KCl - 1,44 g Na2HPO4 - 0,24 g KH2PO4 - nước cất 1 lít.
2.3. Phương pháp nghiên cứu
2.3.1. Phương pháp thu nhận sinh khối vi sinh vật
Nuôi cấy các chủng vi khuẩn, xạ khuẩn trên môi trường GYP dịch thể ở điều kiện 30oC, tốc độ lắc 180 vòng/phút, trong 24 giờ (vi khuẩn) hoặc trong 48 giờ (xạ khuẩn). Hút 1000 µL dịch nuôi cấy vào từng ống Eppendorf, ly tâm 10 000 vòng/phút ở 4oC, loại bỏ dịch và thu sinh khối.
2.3.2. Kỹ thuật bảo quản đông khô
Mỗi ống Cryotube chứa sinh khối mỗi chủng và 200 µL dung dịch chất bảo vệ sau đó tiền xử lý ở nhiệt độ - 20oC trong 12 giờ. Đặt các ống Cryotube vào thiết bị đông khô theo chế độ như sau: nhiệt độ bình ngưng -51oC, áp suất buồng đông khô 5 Pa trong 24 giờ [16]. Kết hợp đông khô mẫu đối chứng có sinh khối vi sinh vật không qua bước tiền xử lý.
2.3.3. Xây dựng công thức chứa thành phần chất bảo vệ khác nhau đến chất lượng bảo quản
- Mỗi chất bảo vệ khác nhau: skim milk, trehalose, lactose, sucrose (10%, w/v) được sử dụng trong thí nghiệm.
- Đồng thời xây dựng 4 hỗn hợp chứa các chất bảo vệ như sau: HH1 (Trehalose 10% + skim milk 10%); HH2 (Trehalose 10% + skim milk 10% + NaCl 0,9%); HH3 (Trehalose 10% + skim milk 10% + natri glutamat 1%) và HH4 (Trehalose 10% + skim milk 10% + natri glutamat 1% + NaCl 0,9%).
Sau đó bổ sung 200 µL dung dịch theo các công thức từng chất và hỗn hợp vào từng ống thử nghiệm, vortex nhẹ tạo dịch huyền phù, sau đó chuyển sang ống Cryotube để tiến hành các thao tác xử lý bảo quản. Các thao tác và dụng cụ thí nghiệm trong các bước đảm bảo vô trùng.
Mẫu đối chứng thay chất bảo vệ bằng dung dịch 0,9% NaCl. Các ống bảo quản được xử lý ở - 80oC trong thời gian 12 giờ trước khi chuyển sang thiết bị đông khô.
Để phục hồi chủng giống sau khi bảo quản bổ sung 200 µL dung dịch đệm PBS, vortex nhẹ và đặt ở nhiệt độ phòng trong 30 phút, sau đó xác định tỷ lệ sống sót của vi sinh vật [2,4].
2.3.4. Phân tích và xử lý số liệu
Tỉ lệ sống sót của mỗi chủng được xác định dựa trên cơ sở đánh giá mật độ vi sinh vật trước và sau đông khô theo phương pháp đếm số lượng đơn vị hình thành đơn vị khuẩn lạc (CFU) trên môi trường thạch GYP ở thời điểm 24 giờ sau khi xử lý lạnh sâu và sau đông khô mẫu. Kết quả được tính toán theo công thức [2, 15]:

Các thí nghiệm được lặp lại 3 lần. Số liệu nghiên cứu được xử lý thống kê sinh học trên phần mền Excel 2010.
3. KẾT QUẢ NGHIÊN CỨU VÀ THẢO LUẬN
3.1. Ảnh hưởng của điều kiện tiền xử lý lạnh sâu tới khả năng sống sót của chủng vi khuẩn ĐL01.B09 và xạ khuẩn TA3.A03 sau đông khô
Kết quả nghiên cứu thể hiện ở Hình 1.A và 1.B cho thấy ảnh hưởng của điều kiện xử lý lạnh sâu trước khi đông khô đến tỷ lệ sống sót của các vi sinh vật nghiên cứu. Cụ thể, khi các tế bào được xử lý lạnh sâu ở -80°C hoặc -20°C thì tỷ lệ sống sót sau quá trình đông khô của cả hai chủng đều cao hơn so với đối chứng mẫu không qua xử lý lạnh sâu, đạt 71% với xạ khuẩn, 73% với vi khuẩn khi xử lý lạnh sâu ở -80°C; và đạt 60% với xạ khuẩn, 61% với vi khuẩn khi xử lý lạnh sâu ở -20°C. Trong khi đó ở công thức không xử lý lạnh sâu, tỷ lệ sống sót chỉ đạt 20,5% với xạ khuẩn và 17,6% với vi khuẩn. Mật độ các chủng xạ khuẩn TA3.A03, vi khuẩn ĐL01.B09 sau khi xử lý lạnh sâu ở -80°C đạt 2,1 × 108 CFU/mL và 3,1 × 108 CFU/mL, trong khi mật độ các chủng này chỉ đạt 1,8× 106 - 2,9 × 106 CFU/mL khi xử lý lạnh sâu ở -20°C. Như vậy, xử lý lạnh sâu ở -80°C cho tỷ lệ sống sót của các chủng vi khuẩn và xạ khuẩn sau đông khô cao hơn so với xử lý lạnh sâu ở -20°C. Kết quả nghiên cứu tương tự cũng đã được Zhao và cộng sự (2005) công bố và xác định mẫu vi khuẩn Lactobacillus brevis được xử lý lạnh sâu ở -65°C có tỷ lệ sống sót sau đông khô đạt 65% cao hơn so với xử lý lạnh sâu ở -20°C (tỷ lệ sống sót đạt 46%) [4].


Hình 1. Ảnh hưởng của tiền xử lý lạnh sâu tới (A) mật độ (Log CFU/mL) và (B) tỷ lệ sống sót (%) của các mẫu đông khô chủng vi khuẩn và xạ khuẩn
3.2. Ảnh hưởng của các chất bảo vệ tới khả năng sống sót của chủng vi khuẩn ĐL01.B09 và xạ khuẩn TA3.A03 sau đông khô
Tác động riêng rẽ của việc sử dụng lactose, sucrose, trehalose và skim milk (10%, w/v) như là chất bảo vệ đối với khả năng sống sót của chủng vi khuẩn và xạ khuẩn nghiên cứu so với đối chứng (chỉ sử dụng nước muối sinh lý khử trùng NaCl 0,9%) được đánh giá ở cùng điều kiện xử lý lạnh sâu -80°C trong 12h trước khi chuyển tiếp sang thiết bị đông khô. Kết quả thể hiện ở Hình 2.A và 2.B cho thấy, có sự khác biệt về khả năng tồn tại của các chủng vi khuẩn, xạ khuẩn sau đông khô khi sử dụng các chất bảo vệ khác nhau, trong đó tỷ lệ sống sót cao nhất được xác định khi sử dụng chất bảo vệ là trehalose, đạt 79% và 80%, cao hơn so với sử dụng skim milk (71% và 73%), sucrose (57% và 59%), lactose (52% và 51%) và cao hơn có ý nghĩa thống kê so với đối chứng sử dụng NaCl 0,9% (21% và 18%). Mật độ chủng xạ khuẩn TA3.A03, vi khuẩn ĐL01.B09 sau đông khô sử dụng trehalose đạt 8,5 × 108 CFU/mL và 1,2 × 109 CFU/mL. Sử dụng chất bảo vệ skim milk 10% mật độ xạ khuẩn TA3.A03, vi khuẩn ĐL01.B09 sau đông khô nằm trong khoảng 1,3-3,6 × 108 CFU/mL.
Một số nghiên cứu đã báo cáo tác động tích cực của trehalose so với một số chất bảo vệ khác đối với sự tồn tại của vi sinh vật trong bảo quản lạnh sâu và đông khô [4, 5] và xác định trehalose 10% đã làm tăng tỷ lệ sống sót của các chủng vi khuẩn Lactobacillus brevis và Oenococcus oeni lên 56,8% và 40,2% so với lactose, sucrose, maltose, glucose, fructose [4]. Điều này được lý giải có thể do tác động liên kết giữa phân tử đường trehalose và các nhóm đầu phân cực của phân tử phospholipid kép ở trên màng tế bào giúp bảo vệ màng tế bào. Ngược lại, trong trường hợp không sử dụng chất bảo quản trehalose hay các chất bảo vệ khác, các tế bào bị tổn thương sau khi làm lạnh sâu và đông khô do sự hình thành tinh thể băng, tỷ lệ sống sót ghi nhận chỉ đạt 8,7%-19% so với trước khi bảo quản đối với các mẫu đối chứng chỉ bổ sung NaCl 0,9% [8, 9, 10]. Ngoài ra loại đường này cũng được biết đến như một chất chống oxy hóa bảo vệ màng chống lại stress oxy hóa [6, 7].

Hình 2. Ảnh hưởng của chất bảo vệ tới (A) mật độ tế bào (Log CFU/mL) và (B) tỷ lệ sống sót (%) của chủng vi khuẩn và xạ khuẩn sau đông khô
3.3. Ảnh hưởng của các công thức bảo quản khác nhau tới khả năng tồn tại của chủng giống vi sinh vật sau đông khô
Hai chủng TA3.A03 và ĐL01.B09 được thử nghiệm bảo quản với 4 công thức môi trường thử nghiệm trên thiết bị đông khô chuyên dụng của đơn vị (áp dụng bước tiền xử lý lạnh sâu ở -80°C). Kết quả trên Hình 3.A và 3.B chỉ ra cả 4 công thức môi trường bảo vệ sử dụng đều cho hiệu quả bảo vệ cao, thể hiện ở tỉ lệ sống sót của cả 2 chủng giống sau 24 giờ xử lý đông khô đạt từ 78 - 91%, cao hơn gấp khoảng 4 lần so với mẫu đối chứng chỉ đạt 18% - 19%. Trong đó, công thức môi trường bảo vệ HH4 gồm các thành phần: Trehalose 10% + skim milk 10% + natri glutamat 1% + NaCl 0.9% cho hiệu quả bảo vệ cao nhất, thể hiện ở tỉ lệ sống sót đạt 91% đối với mẫu xạ khuẩn và 88% đối với mẫu vi khuẩn, giá trị Log(CFU/mL) đạt 10,4 và 10,2, tương ứng mật độ tế bào đạt 4,9×1010 CFU/mL và 2,6×1010 CFU/mL. Điều này cho thấy, việc sử dụng kết hợp bổ sung đồng thời các chất bảo vệ là trehalose và skim milk cùng với NaCl 0,9% và natri glutamat 1% có tác dụng nâng cao tỉ lệ sống sót của hai chủng nghiên cứu sau đông khô tốt hơn so với các mẫu được xử lý với HH1, HH2, HH3 và so với mẫu được xử lý với các chất đơn lẻ (Hình 2.A và Hình 2.B). Kết quả nghiên cứu của chúng tôi cũng phù hợp với một số nghiên cứu đã chỉ ra, môi trường bảo vệ có sự kết hợp đồng thời của một số chất bảo vệ cho tỷ lệ sống sót cao hơn khi sử dụng môi trường chỉ chứa riêng lẻ một chất trong quá trình bảo quản đông khô [1, 3, 11]. Việc sử dụng 10% trehalose làm chất bảo vệ giúp duy trì khả năng sống sót đạt 74%, trong khi đó sự kết hợp của trehalose với skim milk và natri glutamat làm tăng khả năng sống sót của chủng vi khuẩn lên 85% sau khi đông khô cũng được công bố [2]. Trong nghiên cứu này, việc kết hợp của trehalose với skim milk và natri glutamat (HH3) cũng cho hiệu quả đông khô cao, thể hiện ở tỷ lệ sống sót sau 24 giờ đông khô các chủng xạ khuẩn đạt 81%, các chủng vi khuẩn đạt 83%. Tuy nhiên, các chủng vi sinh vật nghiên cứu có nguồn gốc phân lập từ môi trường biển nên việc bổ sung thêm một tỷ lệ NaCl 0,9% (ở HH4) có tác dụng nâng cao hiệu quả của bảo quản đông khô đối với các chủng giống này hơn so với khi xử lý với HH3 (Hình 3.A và Hình 3.B).

Hình 3. Ảnh hưởng của các công thức phối hợp các chất bảo quản tới (A) mật độ tế bào (Log CFU/mL) và (B) tỷ lệ sống sót (%)
của chủng vi khuẩn và xạ khuẩn sau đông khô
3.4. Đánh giá chất lượng bảo quản chủng giống vi khuẩn và xạ khuẩn theo thời gian
Đánh giá chất lượng bảo quản chủng giống xạ khuẩn và vi khuẩn theo thời gian được dựa trên các tiêu chí về khả năng tồn tại và tính ổn định hoạt tính enzym của chủng giống trong các ống đông khô được bảo quản ở nhiệt độ phòng. Kết quả trình bày trong Bảng 1 cho thấy, mật độ tế bào ngay sau khi xử lý đông khô đều đạt trên 1010 CFU/mL và mật độ tế bào vẫn duy trì ở mức > 1010 CFU/mL tại các thời điểm kiểm tra 1 tháng, 3 tháng và 6 tháng sau đông khô. Từ tháng thứ 9 đến tháng thứ 15 mật độ tế bào vẫn còn duy trì ở mức > 109 CFU/mL và không phát hiện vi sinh vật tạp lẫn trong mẫu bảo quản, đáp ứng TCVN 6168 - 2002, chế phẩm vi sinh vật sau bảo quản phải đạt mật độ vi sinh vật tuyển chọn không nhỏ hơn 1,0 ×108 CFU/mL. Đồng thời kết quả đánh giá hoạt tính enzym theo thời gian bảo quản cho thấy chủng xạ khuẩn TA3.A03 và vi khuẩn ĐL01.B09 vẫn duy trì được hoạt tính enzym ngoại bào cellulase, amylase và protease thể hiện thông qua đường kính vòng phân giải các cơ chất tương ứng cellulose, tinh bột và gelatin đạt ≥ 10 mm, ổn định so với hoạt tính enzym ở thời điểm phân lập ban đầu (Hình 4) [12, 13]. Như vậy, trong nghiên cứu này, chất lượng bảo quản 2 chủng vi sinh vật biển gồm xạ khuẩn TA3.A03 và vi khuẩn ĐL01.B09 theo phương pháp đông khô đảm bảo yêu cầu quy định tại TCVN 6168 - 2002 sau 15 tháng bảo quản ở điều kiện nhiệt độ phòng.
Bảng 1. Chất lượng bảo quản chủng giống xạ khuẩn và vi khuẩn theo thời gian

Ghi chú: + Đường kính vòng phân giải cơ chất cellulose, tinh bột, gelatin ≥ 10 mm.
Hình 4. Hoạt tính enzym cellulase và amylase của hai chủng vi khuẩn và xạ khuẩn sau đông khô
4. KẾT LUẬN
- Tỷ lệ sống sót của 2 chủng B. amyloliquefaciens ĐL01.B09 và Streptomyces sp. TA3.A03 khi được xử lý mẫu lạnh sâu ở nhiệt độ -80°C cao hơn so với ở -20°C và cao hơn đối chứng không xử lý lạnh sâu. Việc kết hợp xử lý lạnh sâu ở -80°C kết hợp với sử dụng các chất bảo vệ lactose, sucrose, trehalose, skim milk (10%) giúp nâng cao tỷ lệ sống sót của 2 chủng nghiên cứu, đạt 51% và 80%. Trong đó trehalose cho hiệu quả bảo vệ cao nhất, đạt tỷ lệ sống sót 79% với mẫu xạ khuẩn và 80% với mẫu vi khuẩn.
- Hiệu quả bảo quản tốt nhất ở công thức có sự phối hợp các chất bảo vệ: trehalose 10%, skim milk 10%, natri glutamat 1% và NaCl 0,9% kết hợp tiền xử lý lạnh sâu ở -80°C. Tỷ lệ sống sót đạt 91% với mẫu xạ khuẩn và 88% với mẫu vi khuẩn, tương ứng mật độ vi sinh vật sau đông khô đạt ≥ 1010 CFU/mL.
- Chất lượng mẫu vi sinh vật đông khô đảm bảo đạt mật độ vi sinh vật tuyển chọn lớn hơn 1,0 ×108 CFU/mL phù hợp theo quy định tại TCVN 6168 - 2002 sau 15 tháng bảo quản ở điều kiện nhiệt độ phòng.
Tài liệu tham khảo
2. Bellali S., et al., A new protectant medium preserving bacterial viability after freeze drying, Microbiological Research, 2020, 236:126454.
3. Abadias M., et al., Effect of freeze drying and protectants on viability of the biocontrol yeast Candida sake, International Journal of Food Microbiology, 2001, 65(3):173-182.
4. Zhao G., & Zhang G., Effect of protective agents, freezing temperature, rehydration media on viability of malolactic bacteria subjected to freeze-drying, Journal of Applied Microbiology, 2005, 99(2):333-338.
5. Spadaro D., et al., Effect of culture age, protectants, and initial cell concentration on viability of freeze-dried cells of Metschnikowia pulcherrima, Canadian Journal of Microbiology, 2010, 56(10):809-815.
6. Streeter J. G., Effect of trehalose on survival of Bradyrhizobium japonicum during desiccation, Journal of Applied Microbiology, 2003, 95(3):484-491.
7. Herdeiro R. S., Trehalose protects Saccharomyces cerevisiae from lipid peroxidation during oxidative stress, Biochimica et Biophysica Acta (BBA) - General Subjects, 2006, 1760(3):340-346.
8. Miao S., Effect of disaccharides on survival during storage of freeze dried probiotics, Dairy Science and Technology, 2008, 88(1):19-30.
9. Miyamoto-Shinohara Y., et al., Survival rate of microbes after freeze-drying and long-term storage, Cryobiology, 2000, 41(3):251-5.
10. Asada R., et al., Trehalose accumulation and radiation resistance due to prior heat stress in Saccharomyces cerevisiae, Arch. Microbiol., 2022, 204(5):275.
11. Brogna R., et al., Increasing storage stability of freeze-dried plasma using trehalose, PLOS ONE, 2020, 15(6):e0234502.
12. Đỗ Thị Tuyến và cs., Nghiên cứu đa dạng vi khuẩn trong trầm tích biển tại Quần đảo Trường Sa bằng phương pháp truyền thống kết hợp kỹ thuật điện di biến tính, Tạp chí Khoa học và Công nghệ nhiệt đới, 2021, 24:131-143.
13. Do Thi Tuyen, Do Thu Hong, Characterization of actinomycetes strain TA3.A03 isolated from marine sediment of Vietnam, TNU Journal of Science and Technology, 2021, 226(09):204-211.
14. Do Thi Tuyen, Le Van Thang, George Boukharev, Effects of freezing treatments and protective agents on the stability of Weissella cibaria TSL24.10 after freeze-drying, Moscow University Biologica Sciences Bulletin, 2022, 77(4):272-278.
15. Alonso S., Novel preservation techniques for microbial cultures, Food Engineering Series, 2016, 2:7-33.
16. Dương Văn Hợp, Nguyễn Lân Dũng, Giới thiệu một số kỹ thuật bảo quản vi sinh vật, 2007. http://vietsciences.org.